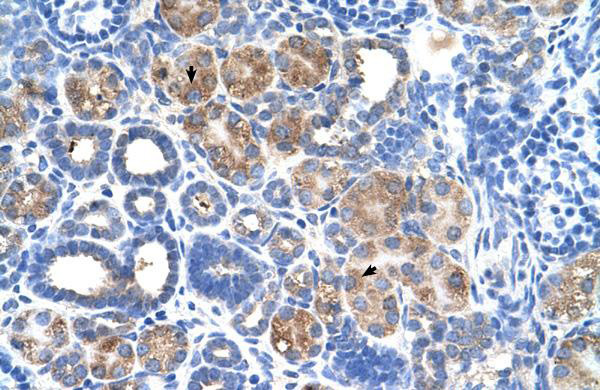

C5ORF4 (FAXDC2) Rabbit Polyclonal Antibody
CAT#: TA329495
Rabbit Polyclonal anti-C5orf4 antibody
Need it in bulk or conjugated?
Get a free quote
CNY 5250.00
货期*
6周
规格
推荐一起购买 (1)
beta Actin Mouse Monoclonal Antibody, Clone OTI1, Loading Control
CNY 300.00
CNY 1430.00
Specifications
| Product Data | |
| Applications | IHC, WB |
| Recommend Dilution | WB, IHC |
| Reactivity | Human |
| Host | Rabbit |
| Clonality | Polyclonal |
| Immunogen | The immunogen for anti-C5orf4 antibody: synthetic peptide directed towards the N terminal of human C5orf4. Synthetic peptide located within the following region: MKGEAGHMLHNEKSKQEGHIWGSMRRTAFILGSGLLSFVAFWNSVTWHLQ |
| Isotype | IgG |
| Formulation | Liquid. Purified antibody supplied in 1x PBS buffer with 0.09% (w/v) sodium azide and 2% sucrose. |
| Conjugation | Unconjugated |
| Storage Condition | Store at -20°C as received. |
| Predicted Protein Size | 21 kDa |
| Gene Name | fatty acid hydroxylase domain containing 2 |
| Database Link | |
| Background | The function remains unknown. |
| Synonyms | C5orf4 |
| Note | Immunogen sequence homology: Dog: 100%; Pig: 100%; Horse: 100%; Human: 100%; Rabbit: 93%; Rat: 92%; Guinea pig: 92% |
| Reference Data | |
| Protein Families | Transmembrane |
Documents
| Product Manuals |
| FAQs |
| SDS |
Resources
| 抗体相关资料 |
Customer
Reviews
Loading...